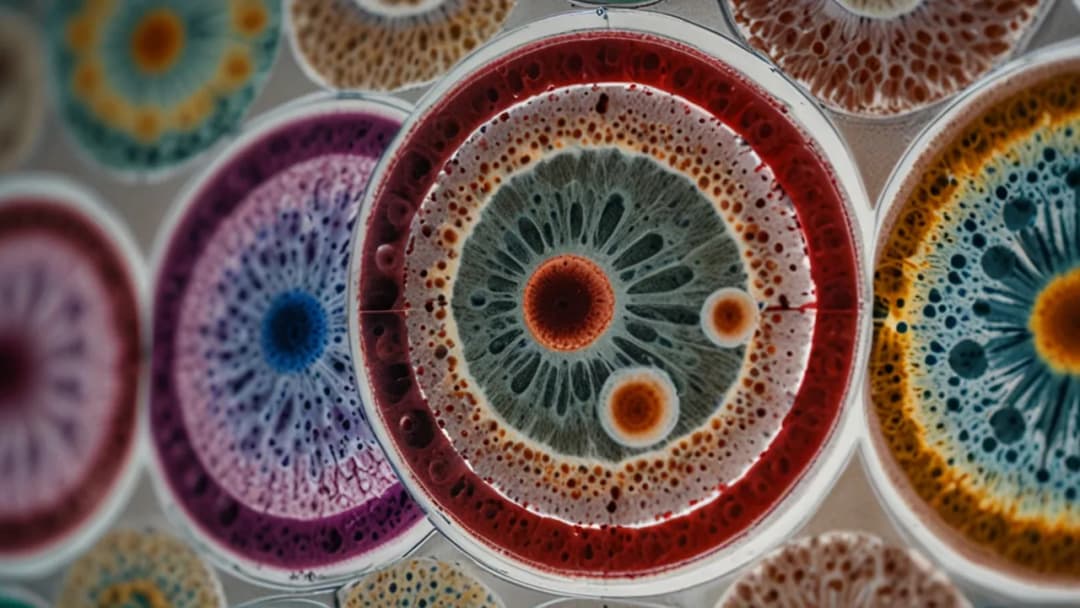
Badanie na candidę: 5 kluczowych faktów dla pacjentów

Dowiedz się, jak wygląda Helicobacter test z kału i co może wykryć. Poznaj procedurę badania, interpretację wyników oraz znaczenie wykrywania H. pylori dla Twojego zdrowia.
Cześć! Jestem Natalia, dietetyczka i trenerka osobista. Moją misją jest edukowanie o zdrowym stylu życia poprzez zbilansowaną dietę i regularną aktywność fizyczną. Specjalizuję się w opracowywaniu indywidualnych planów żywieniowych, które wspierają zarówno zdrowie psychiczne, jak i fizyczne. Na moim blogu znajdziesz przepisy bogate w witaminy i minerały, praktyczne porady na temat suplementacji oraz aktualne informacje z dziedziny medycyny. Dzielę się wiedzą, która pomaga w walce z chorobami i promuje zdrowy tryb życia.

Dowiedz się, jak wygląda Helicobacter test z kału i co może wykryć. Poznaj procedurę badania, interpretację wyników oraz znaczenie wykrywania H. pylori dla Twojego zdrowia.

Ból brzucha u dzieci może być niepokojący. Dowiedz się, kiedy to normalny objaw, a kiedy powód do wizyty u lekarza. Poznaj skuteczne sposoby na złagodzenie bólu i zapobieganie nawrotom.

Odkryj przyczyny bólu brzucha po probiotyku i skuteczne sposoby jego łagodzenia. Dowiedz się, kiedy to normalne, a kiedy warto skonsultować się z lekarzem. Praktyczne porady dla Twojego komfortu!

Biegunka po antybiotyku może być uciążliwa, ale jest na nią rada! Poznaj 5 skutecznych sposobów, które pomogą Ci szybko wrócić do zdrowia. Dowiedz się, jak sobie poradzić z tym problemem.

Odkryj najskuteczniejsze metody badania na pasożyty u dzieci. Od testów kału po analizy krwi - dowiedz się, gdzie zrobić badania i jak zadbać o zdrowie swojego malucha. Sprawdź kompleksowe podejście do diagnostyki!

Dowiedz się, jak przebiega badanie na grzybicę - od przygotowania po interpretację wyników. Poznaj kluczowe etapy diagnostyki, w tym badanie na grzybicę jelit. Skuteczna diagnostyka to podstawa leczenia!

Odkryj moc colostrum! Poznaj 7 kluczowych składników, które wzmocnią Twoją odporność i zdrowie. Colostrum skład i właściwości - dowiedz się, jak może pomóc Twojemu organizmowi. Naturalne wsparcie dla Ciebie!

Odkryj, dlaczego badanie mikrobiomu jelit jest kluczowe dla Twojego zdrowia. Poznaj wpływ mikroflory na odporność, metabolizm i samopoczucie. Dowiedz się, jak to badanie może zmienić Twoje życie.

Poznaj 5 kluczowych faktów o badaniu candida. Dowiedz się, kiedy je wykonać, jak się przygotować i co oznaczają wyniki. Skuteczna diagnostyka i leczenie infekcji grzybiczych.
Dowiedz się, jak przebiega badanie lamblia - od przygotowania po interpretację wyników. Poznaj kluczowe etapy procesu diagnostycznego i skuteczne metody wykrywania tego pasożyta. Zadbaj o swoje zdrowie!